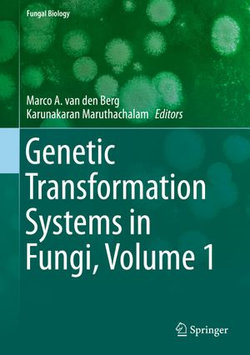

Several different transformation techniques have been developed over the years and readily shown to be decisive methods in fungal biotechnology. This book will cover the basics behind the most commonly used transformation methods, as well as associated tools and techniques. Each chapter will provide protocols along with examples used in laboratories worldwide.
Not only will this text provide a detailed background on applications in industrial and pharmaceutical relevant microbes, but also the importance of fungal pathogens in agricultural production (Phytophthora and Botrytis) and mammalian infection (Penicillium marneffei and Candida). Genetic Transformation Systems in Fungi, Volume 1 provides in-depth coverage of how the transformation of DNA is used to understand the genetic basis behind these fungal traits.

Share This eBook: